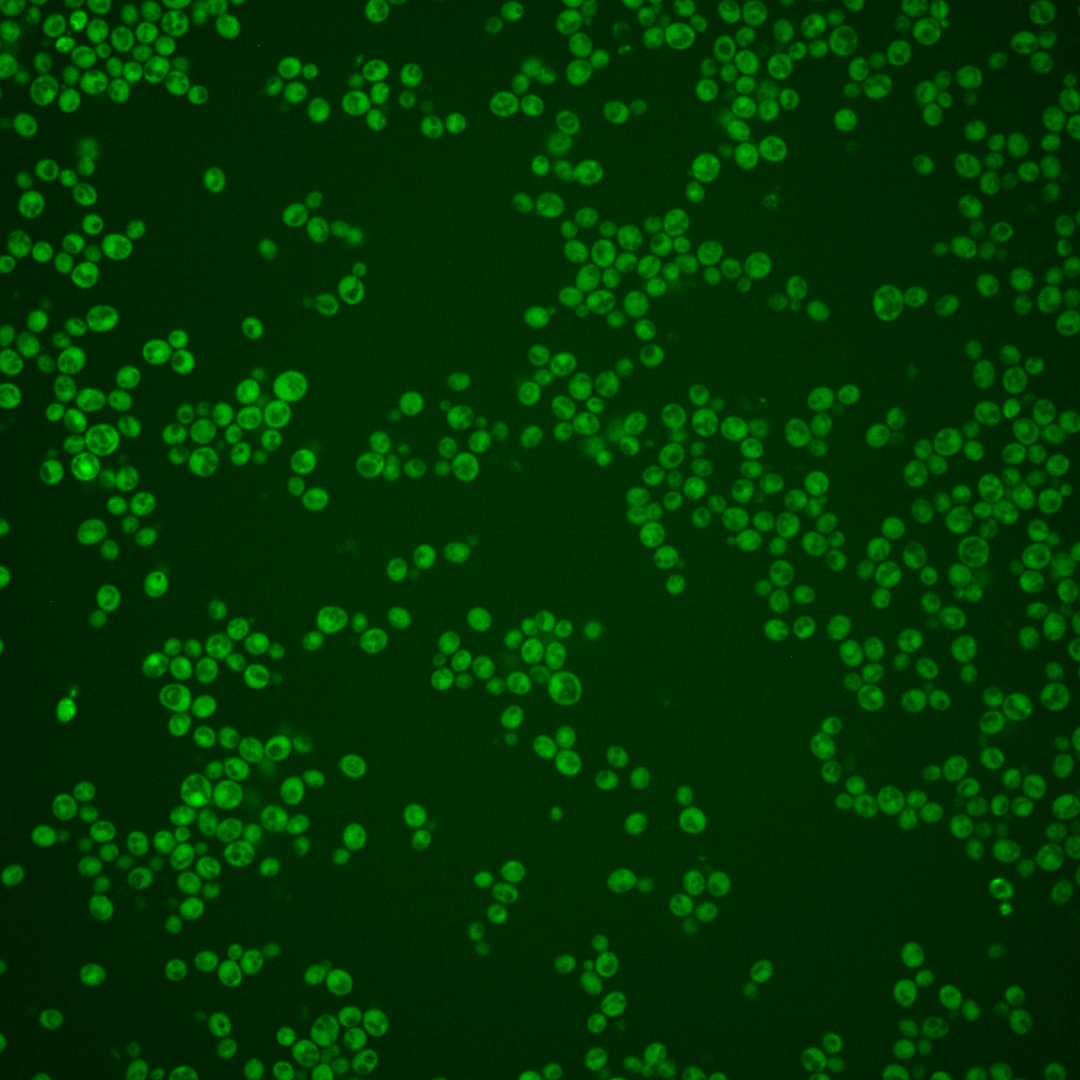
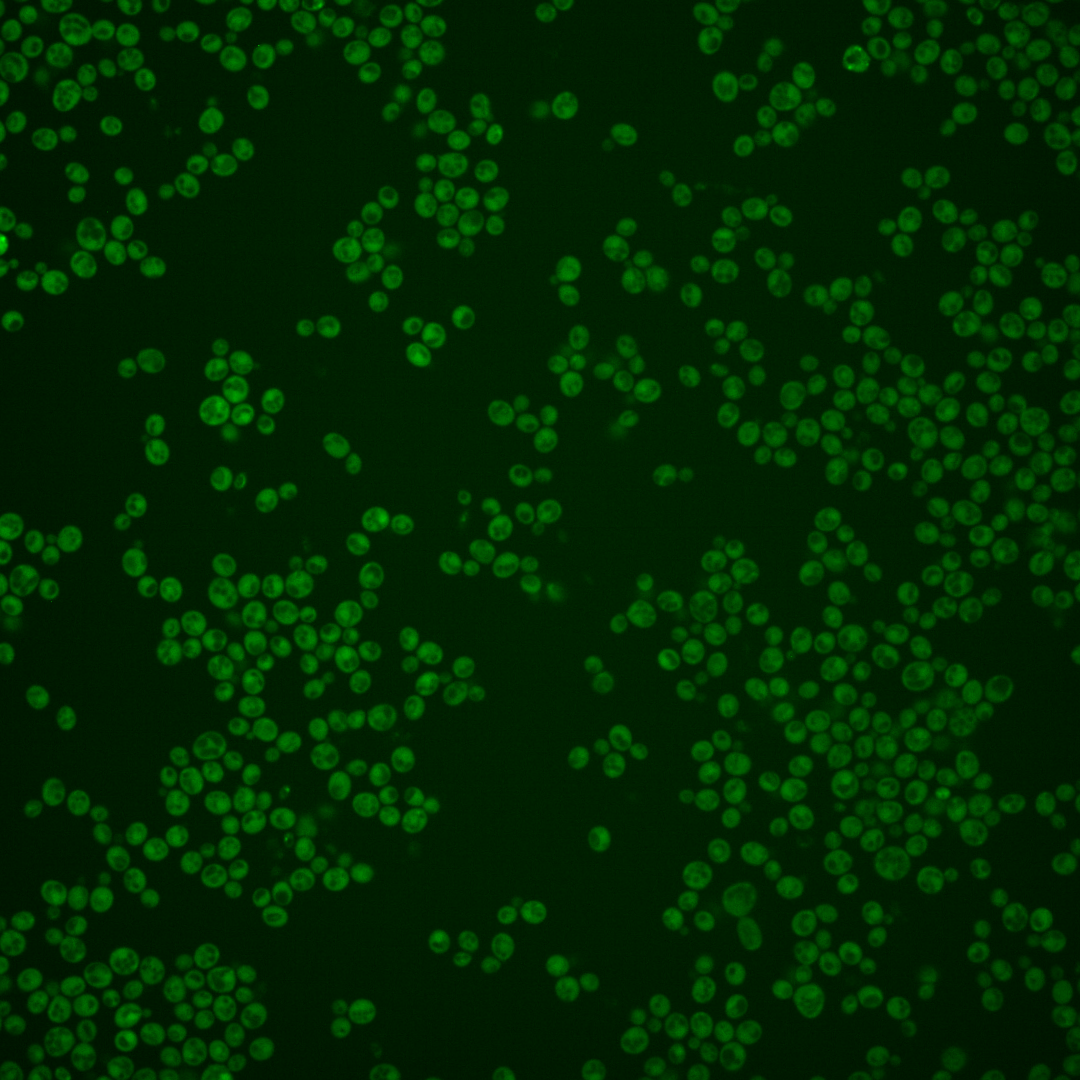
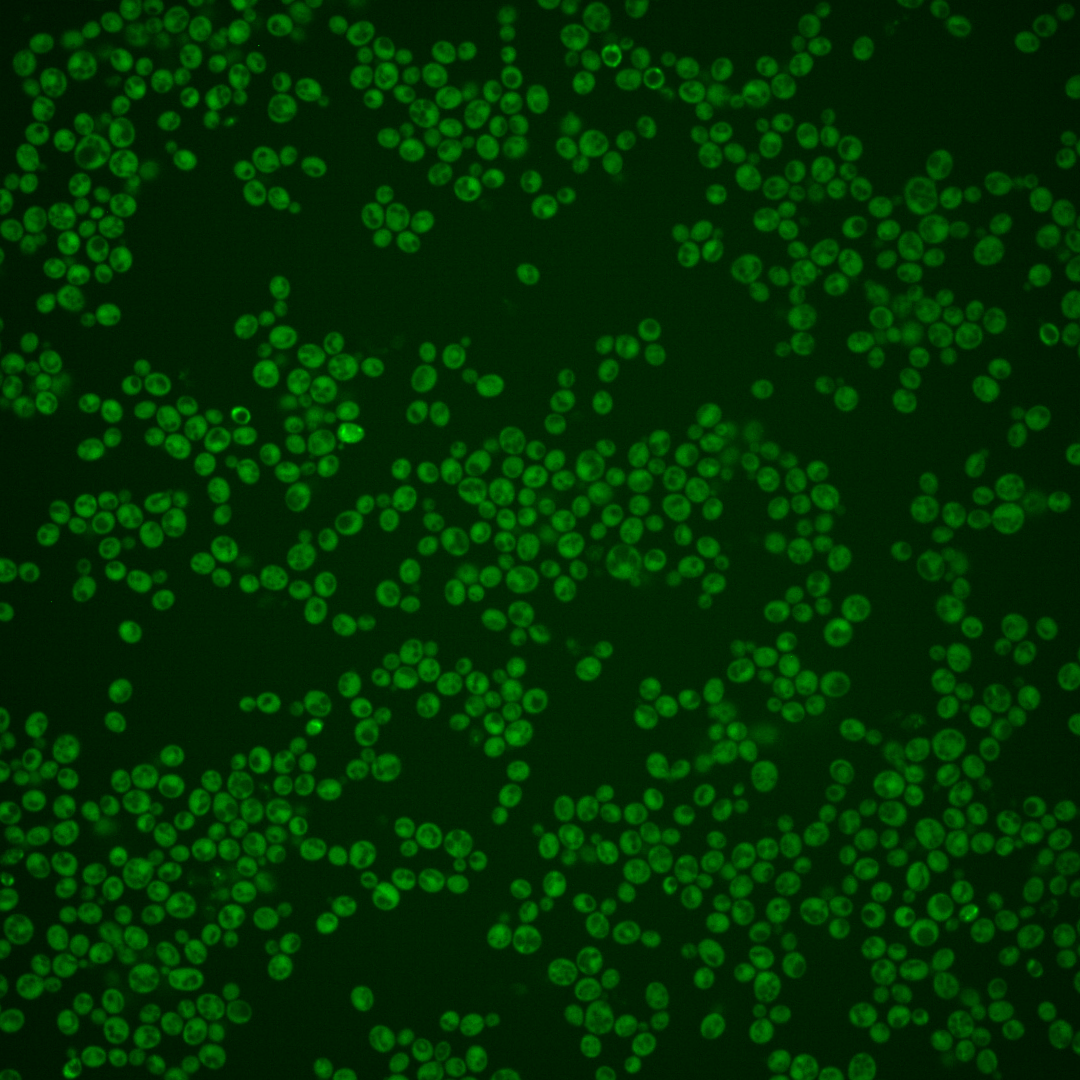

| Standard name | |
|---|---|
| Human Ortholog | |
| Description | PAS domain-containing serine/threonine protein kinase; coordinately regulates protein synthesis and carbohydrate metabolism and storage in response to a unknown metabolite that reflects nutritional status; PSK1 has a paralog, PSK2, that arose from the whole genome duplication |
Micrographs




















































































Sub-cellular Localization
Yeast GFP Assignment
Protein Abundance
Localization Change
External localization resources
| ensLOC | DeepLoc | |||||||||||||||||||||||
|---|---|---|---|---|---|---|---|---|---|---|---|---|---|---|---|---|---|---|---|---|---|---|---|---|
| Localization | WT1 | WT2 | WT3 | RAP60 | RAP140 | RAP220 | RAP300 | RAP380 | RAP460 | RAP540 | RAP620 | RAP700 | HU80 | HU120 | HU160 | rpd3Δ_1 | rpd3Δ_2 | rpd3Δ_3 | WT1 | WT2 | WT3 | AF100 | AF140 | AF180 |
| Cortical Patches | 0 | 1 | 0 | 0 | 0 | 0 | 0 | 0 | 0 | 0 | 0 | 0 | 0 | 0 | 0 | 0 | 1 | 0 | 1 | 2 | 0 | 0 | 1 | 2 |
| Bud | 0 | 3 | 4 | 0 | 0 | 5 | 1 | 2 | 0 | 4 | 2 | 3 | 1 | 1 | 3 | 0 | 0 | 0 | 0 | 4 | 0 | 1 | 1 | 1 |
| Bud Neck | 1 | 1 | 0 | 0 | 0 | 0 | 0 | 0 | 0 | 0 | 0 | 0 | 0 | 0 | 0 | 0 | 0 | 0 | 1 | 1 | 0 | 0 | 0 | 1 |
| Bud Site | 0 | 0 | 0 | 0 | 0 | 0 | 0 | 1 | 0 | 0 | 0 | 0 | 0 | 0 | 1 | 0 | 0 | 0 | – | – | – | – | – | – |
| Cell Periphery | 16 | 1 | 1 | 0 | 1 | 4 | 0 | 3 | 3 | 3 | 3 | 2 | 3 | 5 | 11 | 10 | 4 | 9 | 0 | 0 | 0 | 0 | 0 | 0 |
| Cytoplasm | 546 | 407 | 131 | 90 | 115 | 153 | 170 | 231 | 90 | 92 | 38 | 81 | 224 | 274 | 285 | 165 | 73 | 116 | 537 | 387 | 118 | 192 | 277 | 248 |
| Endoplasmic Reticulum | 6 | 2 | 1 | 1 | 0 | 0 | 0 | 2 | 0 | 0 | 0 | 0 | 0 | 0 | 0 | 4 | 6 | 5 | 0 | 1 | 2 | 1 | 4 | 1 |
| Endosome | 2 | 0 | 0 | 0 | 0 | 0 | 0 | 0 | 0 | 0 | 0 | 0 | 0 | 0 | 0 | 1 | 0 | 0 | 6 | 4 | 1 | 0 | 1 | 5 |
| Golgi | 2 | 0 | 0 | 1 | 0 | 0 | 0 | 0 | 0 | 0 | 0 | 0 | 0 | 0 | 0 | 0 | 0 | 0 | 2 | 1 | 0 | 0 | 2 | 1 |
| Mitochondria | 3 | 12 | 7 | 14 | 9 | 33 | 83 | 72 | 52 | 53 | 26 | 57 | 0 | 0 | 2 | 6 | 4 | 2 | 7 | 7 | 14 | 2 | 4 | 1 |
| Nucleus | 0 | 0 | 0 | 0 | 0 | 1 | 0 | 1 | 1 | 1 | 1 | 2 | 1 | 0 | 3 | 6 | 2 | 0 | 0 | 1 | 0 | 0 | 0 | 0 |
| Nuclear Periphery | 1 | 1 | 0 | 0 | 0 | 0 | 0 | 0 | 0 | 0 | 0 | 0 | 0 | 0 | 1 | 0 | 0 | 0 | 1 | 0 | 0 | 0 | 1 | 0 |
| Nucleolus | 0 | 0 | 1 | 0 | 0 | 0 | 0 | 0 | 0 | 0 | 0 | 0 | 1 | 0 | 0 | 0 | 0 | 0 | 0 | 0 | 0 | 0 | 0 | 0 |
| Peroxisomes | 0 | 0 | 0 | 0 | 0 | 0 | 0 | 0 | 0 | 0 | 0 | 0 | 0 | 0 | 0 | 0 | 0 | 0 | 0 | 0 | 0 | 0 | 0 | 0 |
| SpindlePole | 0 | 0 | 1 | 0 | 0 | 0 | 0 | 1 | 0 | 0 | 1 | 0 | 0 | 0 | 0 | 0 | 1 | 0 | 0 | 1 | 0 | 0 | 0 | 0 |
| Vac/Vac Membrane | 1 | 1 | 0 | 0 | 0 | 0 | 1 | 0 | 0 | 1 | 2 | 1 | 0 | 0 | 0 | 10 | 2 | 5 | 0 | 4 | 10 | 8 | 1 | 3 |
| Unique Cell Count | 555 | 420 | 137 | 94 | 116 | 161 | 206 | 263 | 107 | 121 | 51 | 110 | 225 | 274 | 287 | 177 | 79 | 121 | 563 | 425 | 153 | 209 | 298 | 271 |
| Labelled Cell Count | 578 | 429 | 146 | 106 | 125 | 196 | 255 | 313 | 146 | 154 | 73 | 146 | 230 | 280 | 306 | 202 | 93 | 137 | 563 | 425 | 153 | 209 | 298 | 271 |
Yeast GFP Assignment
Protein Abundance
| Screen | WT1 | WT2 | WT3 | RAP60 | RAP140 | RAP220 | RAP300 | RAP380 | RAP460 | RAP540 | RAP620 | RAP700 | HU80 | HU120 | HU160 | rpd3Δ_1 | rpd3Δ_2 | rpd3Δ_3 | AF100 | AF140 | AF180 |
|---|---|---|---|---|---|---|---|---|---|---|---|---|---|---|---|---|---|---|---|---|---|
| Mean Cell GFP Intensity (1e-4) | 6.1 | 4.5 | 3.9 | 3.9 | 4.0 | 3.9 | 3.7 | 3.6 | 3.5 | 3.4 | 3.5 | 3.8 | 5.4 | 5.4 | 5.1 | 7.9 | 7.6 | 8.2 | 5.4 | 5.7 | 6.2 |
| Std Deviation (1e-4) | 0.6 | 0.7 | 0.8 | 1.1 | 0.6 | 1.1 | 1.3 | 1.0 | 1.7 | 1.3 | 0.9 | 1.7 | 1.3 | 0.9 | 1.0 | 2.1 | 2.0 | 2.4 | 1.1 | 1.4 | 1.8 |
| Intensity Change (Log2) | – | – | – | 0.01 | 0.05 | 0.01 | -0.08 | -0.12 | -0.16 | -0.2 | -0.17 | -0.05 | 0.47 | 0.48 | 0.39 | 1.01 | 0.95 | 1.07 | 0.46 | 0.56 | 0.68 |
Localization Change
| Localization | RAP60 | RAP140 | RAP220 | RAP300 | RAP380 | RAP460 | RAP540 | RAP620 | RAP700 | HU80 | HU120 | HU160 | rpd3Δ_1 | rpd3Δ_2 | rpd3Δ_3 |
|---|---|---|---|---|---|---|---|---|---|---|---|---|---|---|---|
| Actin | – | – | – | – | – | – | – | – | – | – | – | – | – | – | – |
| Bud | – | – | – | – | – | – | – | – | – | – | – | – | – | – | – |
| Bud Neck | – | – | – | – | – | – | – | – | – | – | – | – | – | – | – |
| Bud Site | – | – | – | – | – | – | – | – | – | – | – | – | – | – | – |
| Cell Periphery | – | – | – | – | – | – | – | – | – | – | – | – | – | – | – |
| Cyto | – | – | – | – | – | – | – | – | – | – | – | – | – | – | – |
| Endoplasmic Reticulum | – | – | – | – | – | – | – | – | – | – | – | – | – | – | – |
| Endosome | – | – | – | – | – | – | – | – | – | – | – | – | – | – | – |
| Golgi | – | – | – | – | – | – | – | – | – | – | – | – | – | – | – |
| Mitochondria | – | – | – | – | – | – | – | – | – | – | – | – | – | – | – |
| Nuclear Periphery | – | – | – | – | – | – | – | – | – | – | – | – | – | – | – |
| Nuc | – | – | – | – | – | – | – | – | – | – | – | – | – | – | – |
| Nucleolus | – | – | – | – | – | – | – | – | – | – | – | – | – | – | – |
| Peroxisomes | – | – | – | – | – | – | – | – | – | – | – | – | – | – | – |
| SpindlePole | – | – | – | – | – | – | – | – | – | – | – | – | – | – | – |
| Vac | – | – | – | – | – | – | – | – | – | – | – | – | – | – | – |
| Cortical Patches | – | – | – | – | – | – | – | – | – | – | – | – | – | – | – |
| Cytoplasm | – | – | – | – | – | – | – | – | – | – | – | – | – | – | – |
| Nucleus | – | – | – | – | – | – | – | – | – | – | – | – | – | – | – |
| Vacuole | – | – | – | – | – | – | – | – | – | – | – | – | – | – | – |
External localization resources
Images






























Protein Concentration and Protein Localization Data
| R1 | R2 | R3 | ||||||||||||||||
|---|---|---|---|---|---|---|---|---|---|---|---|---|---|---|---|---|---|---|
| G1 Pre-START | G1 Post-START | S/G2 | Metaphase | Anaphase | Telophase | G1 Pre-START | G1 Post-START | S/G2 | Metaphase | Anaphase | Telophase | G1 Pre-START | G1 Post-START | S/G2 | Metaphase | Anaphase | Telophase | |
| Concentration | 1.6531 | 2.6287 | 2.2198 | 1.4706 | 1.814 | 2.5969 | 0.2748 | -0.1017 | 0.1307 | -0.0524 | -0.3934 | 0.0983 | 3.5364 | 4.8327 | 4.1509 | 3.808 | 4.1219 | 4.3109 |
| Actin | 0.018 | 0.0003 | 0.0003 | 0.0004 | 0.0014 | 0.0013 | 0.0348 | 0.0017 | 0.0196 | 0.0149 | 0.0067 | 0.007 | 0.0222 | 0.0013 | 0.0073 | 0.0035 | 0.0246 | 0.0034 |
| Bud | 0.0001 | 0.0001 | 0.0001 | 0.0001 | 0.0003 | 0.0001 | 0.0054 | 0.0108 | 0.0124 | 0.0143 | 0.0045 | 0.0027 | 0.0149 | 0.0138 | 0.0011 | 0.0229 | 0.0019 | 0.0078 |
| Bud Neck | 0.0005 | 0.0001 | 0.0002 | 0.0003 | 0.0005 | 0.0012 | 0.0114 | 0.0007 | 0.0069 | 0.0007 | 0.0041 | 0.0125 | 0.0004 | 0.0014 | 0.0005 | 0.0006 | 0.001 | 0.0004 |
| Bud Periphery | 0.0002 | 0 | 0 | 0.0001 | 0.0002 | 0.0002 | 0.0071 | 0.0081 | 0.0151 | 0.0201 | 0.0037 | 0.0032 | 0.0054 | 0.0098 | 0.0019 | 0.0287 | 0.0019 | 0.0045 |
| Bud Site | 0.0007 | 0.0008 | 0.0074 | 0.0001 | 0.0003 | 0.0001 | 0.0119 | 0.0283 | 0.0334 | 0.0072 | 0.0301 | 0.002 | 0.0142 | 0.092 | 0.0023 | 0.0092 | 0.002 | 0.0008 |
| Cell Periphery | 0.0007 | 0.0007 | 0.0005 | 0.0002 | 0.0002 | 0.0002 | 0.0009 | 0.0006 | 0.0006 | 0.0004 | 0.0008 | 0.0002 | 0.0008 | 0.0012 | 0.0004 | 0.0001 | 0.0001 | 0.0002 |
| Cytoplasm | 0.7323 | 0.8416 | 0.8233 | 0.975 | 0.8576 | 0.889 | 0.5348 | 0.703 | 0.6525 | 0.676 | 0.6389 | 0.7244 | 0.4441 | 0.5864 | 0.5354 | 0.8198 | 0.6741 | 0.5625 |
| Cytoplasmic Foci | 0.0047 | 0.0035 | 0.0035 | 0.0025 | 0.015 | 0.0049 | 0.0415 | 0.026 | 0.0297 | 0.0288 | 0.0397 | 0.0368 | 0.0181 | 0.0063 | 0.0096 | 0.0288 | 0.0241 | 0.0095 |
| Eisosomes | 0.0004 | 0.0001 | 0.0001 | 0 | 0 | 0.0001 | 0.0002 | 0 | 0.0001 | 0.0001 | 0.0001 | 0 | 0.0005 | 0.0001 | 0.0002 | 0 | 0.0001 | 0.0001 |
| Endoplasmic Reticulum | 0.0081 | 0.003 | 0.0046 | 0.0032 | 0.0059 | 0.0026 | 0.0102 | 0.0023 | 0.0054 | 0.0039 | 0.0034 | 0.0042 | 0.0028 | 0.0058 | 0.0023 | 0.0018 | 0.0034 | 0.0013 |
| Endosome | 0.006 | 0.0018 | 0.0023 | 0.0016 | 0.0309 | 0.0063 | 0.0528 | 0.0226 | 0.0297 | 0.0232 | 0.0438 | 0.0233 | 0.0046 | 0.0033 | 0.0045 | 0.0059 | 0.017 | 0.0023 |
| Golgi | 0.0018 | 0.0002 | 0.0003 | 0.0002 | 0.0011 | 0.0021 | 0.0088 | 0.0019 | 0.0027 | 0.0029 | 0.0017 | 0.0034 | 0.0023 | 0.0004 | 0.0017 | 0.0009 | 0.0022 | 0.0006 |
| Lipid Particles | 0.0007 | 0.0005 | 0.0003 | 0 | 0.0002 | 0.0001 | 0.0132 | 0.0005 | 0.0012 | 0.0009 | 0.0076 | 0.0026 | 0.0035 | 0.0002 | 0.0021 | 0.0001 | 0.0011 | 0.0003 |
| Mitochondria | 0.0008 | 0.0001 | 0.0001 | 0.0001 | 0.0003 | 0.0182 | 0.0095 | 0.0033 | 0.0031 | 0.005 | 0.0011 | 0.0019 | 0.0026 | 0.0004 | 0.0102 | 0.0012 | 0.0034 | 0.0007 |
| None | 0.2206 | 0.1447 | 0.1542 | 0.0133 | 0.0781 | 0.0714 | 0.1722 | 0.1742 | 0.166 | 0.1654 | 0.1779 | 0.1482 | 0.4422 | 0.2723 | 0.4046 | 0.0568 | 0.2227 | 0.3991 |
| Nuclear Periphery | 0.0016 | 0.0003 | 0.0004 | 0.0004 | 0.0008 | 0.0002 | 0.0203 | 0.0008 | 0.003 | 0.0089 | 0.0067 | 0.01 | 0.0005 | 0.001 | 0.0004 | 0.0006 | 0.0016 | 0.0008 |
| Nucleolus | 0.0001 | 0 | 0.0001 | 0 | 0 | 0 | 0.002 | 0.0005 | 0.0006 | 0.001 | 0.0014 | 0.0005 | 0.0005 | 0.0002 | 0.0001 | 0.0002 | 0.0003 | 0.0003 |
| Nucleus | 0.0007 | 0.0005 | 0.0007 | 0.0006 | 0.0007 | 0.0006 | 0.0334 | 0.0028 | 0.0041 | 0.008 | 0.0042 | 0.0046 | 0.0011 | 0.0015 | 0.0006 | 0.0013 | 0.0018 | 0.0018 |
| Peroxisomes | 0.0002 | 0 | 0 | 0 | 0.0001 | 0.0001 | 0.0065 | 0.0015 | 0.0036 | 0.0026 | 0.0015 | 0.004 | 0.0164 | 0.0001 | 0.0126 | 0.0128 | 0.0097 | 0.0009 |
| Punctate Nuclear | 0.0005 | 0.0001 | 0.0002 | 0 | 0.0002 | 0.0002 | 0.0056 | 0.0016 | 0.0018 | 0.0085 | 0.011 | 0.0028 | 0.001 | 0.0008 | 0.0003 | 0.0026 | 0.0037 | 0.0013 |
| Vacuole | 0.0013 | 0.0012 | 0.0012 | 0.0017 | 0.0054 | 0.0007 | 0.0136 | 0.0076 | 0.0069 | 0.0059 | 0.0094 | 0.0045 | 0.0017 | 0.0015 | 0.0016 | 0.0017 | 0.0027 | 0.001 |
| Vacuole Periphery | 0.0002 | 0.0001 | 0.0001 | 0.0001 | 0.0008 | 0.0003 | 0.004 | 0.001 | 0.0015 | 0.0013 | 0.0015 | 0.0011 | 0.0002 | 0.0002 | 0.0003 | 0.0003 | 0.0006 | 0.0003 |
Sequencing Data
| R1 | R2 | |||||||||
|---|---|---|---|---|---|---|---|---|---|---|
| G1 Post-START | S/G2 | Metaphase | Anaphase | Telophase | G1 Post-START | S/G2 | Metaphase | Anaphase | Telophase | |
| Gene Expression | 15.0427 | 19.6258 | 14.3834 | 21.7085 | 17.0436 | 19.5041 | 28.7854 | 30.7545 | 27.4033 | 22.4938 |
| Translational Efficiency | 0.5507 | 0.6191 | 0.5592 | 0.4941 | 0.441 | 0.5394 | 0.4974 | 0.4096 | 0.5212 | 0.4987 |
Hit Data
| Dataset | Hit |
|---|---|
| Protein Concentration | ✘ |
| Protein Localization | ✘ |
| Gene Expression | ✘ |
| Translational Efficiency | ✘ |
Endocytosis
| Temp | Actin Patch (Sac6-tdTomato) | Cortical Patch (Sla1-GFP) | Late Endosome (Snf7-GFP) | Vacuole (Vph1-GFP) |
|---|---|---|---|---|
| 37℃ | ||||
| RT |
Cell Cycle Omics
CYCLoPs (Psk1-GFP)
| Gene / Allele | Actin Patch (Sac6-tdTomato) | Cortical Patch (Sla1-GFP) | Late Endosome (Snf7-GFP) | Vacuole (Sac6-tdTomato) |
|---|
| Gene | Images |
|---|
| Gene | Images |
|---|
Images are not yet available
Images are not yet available